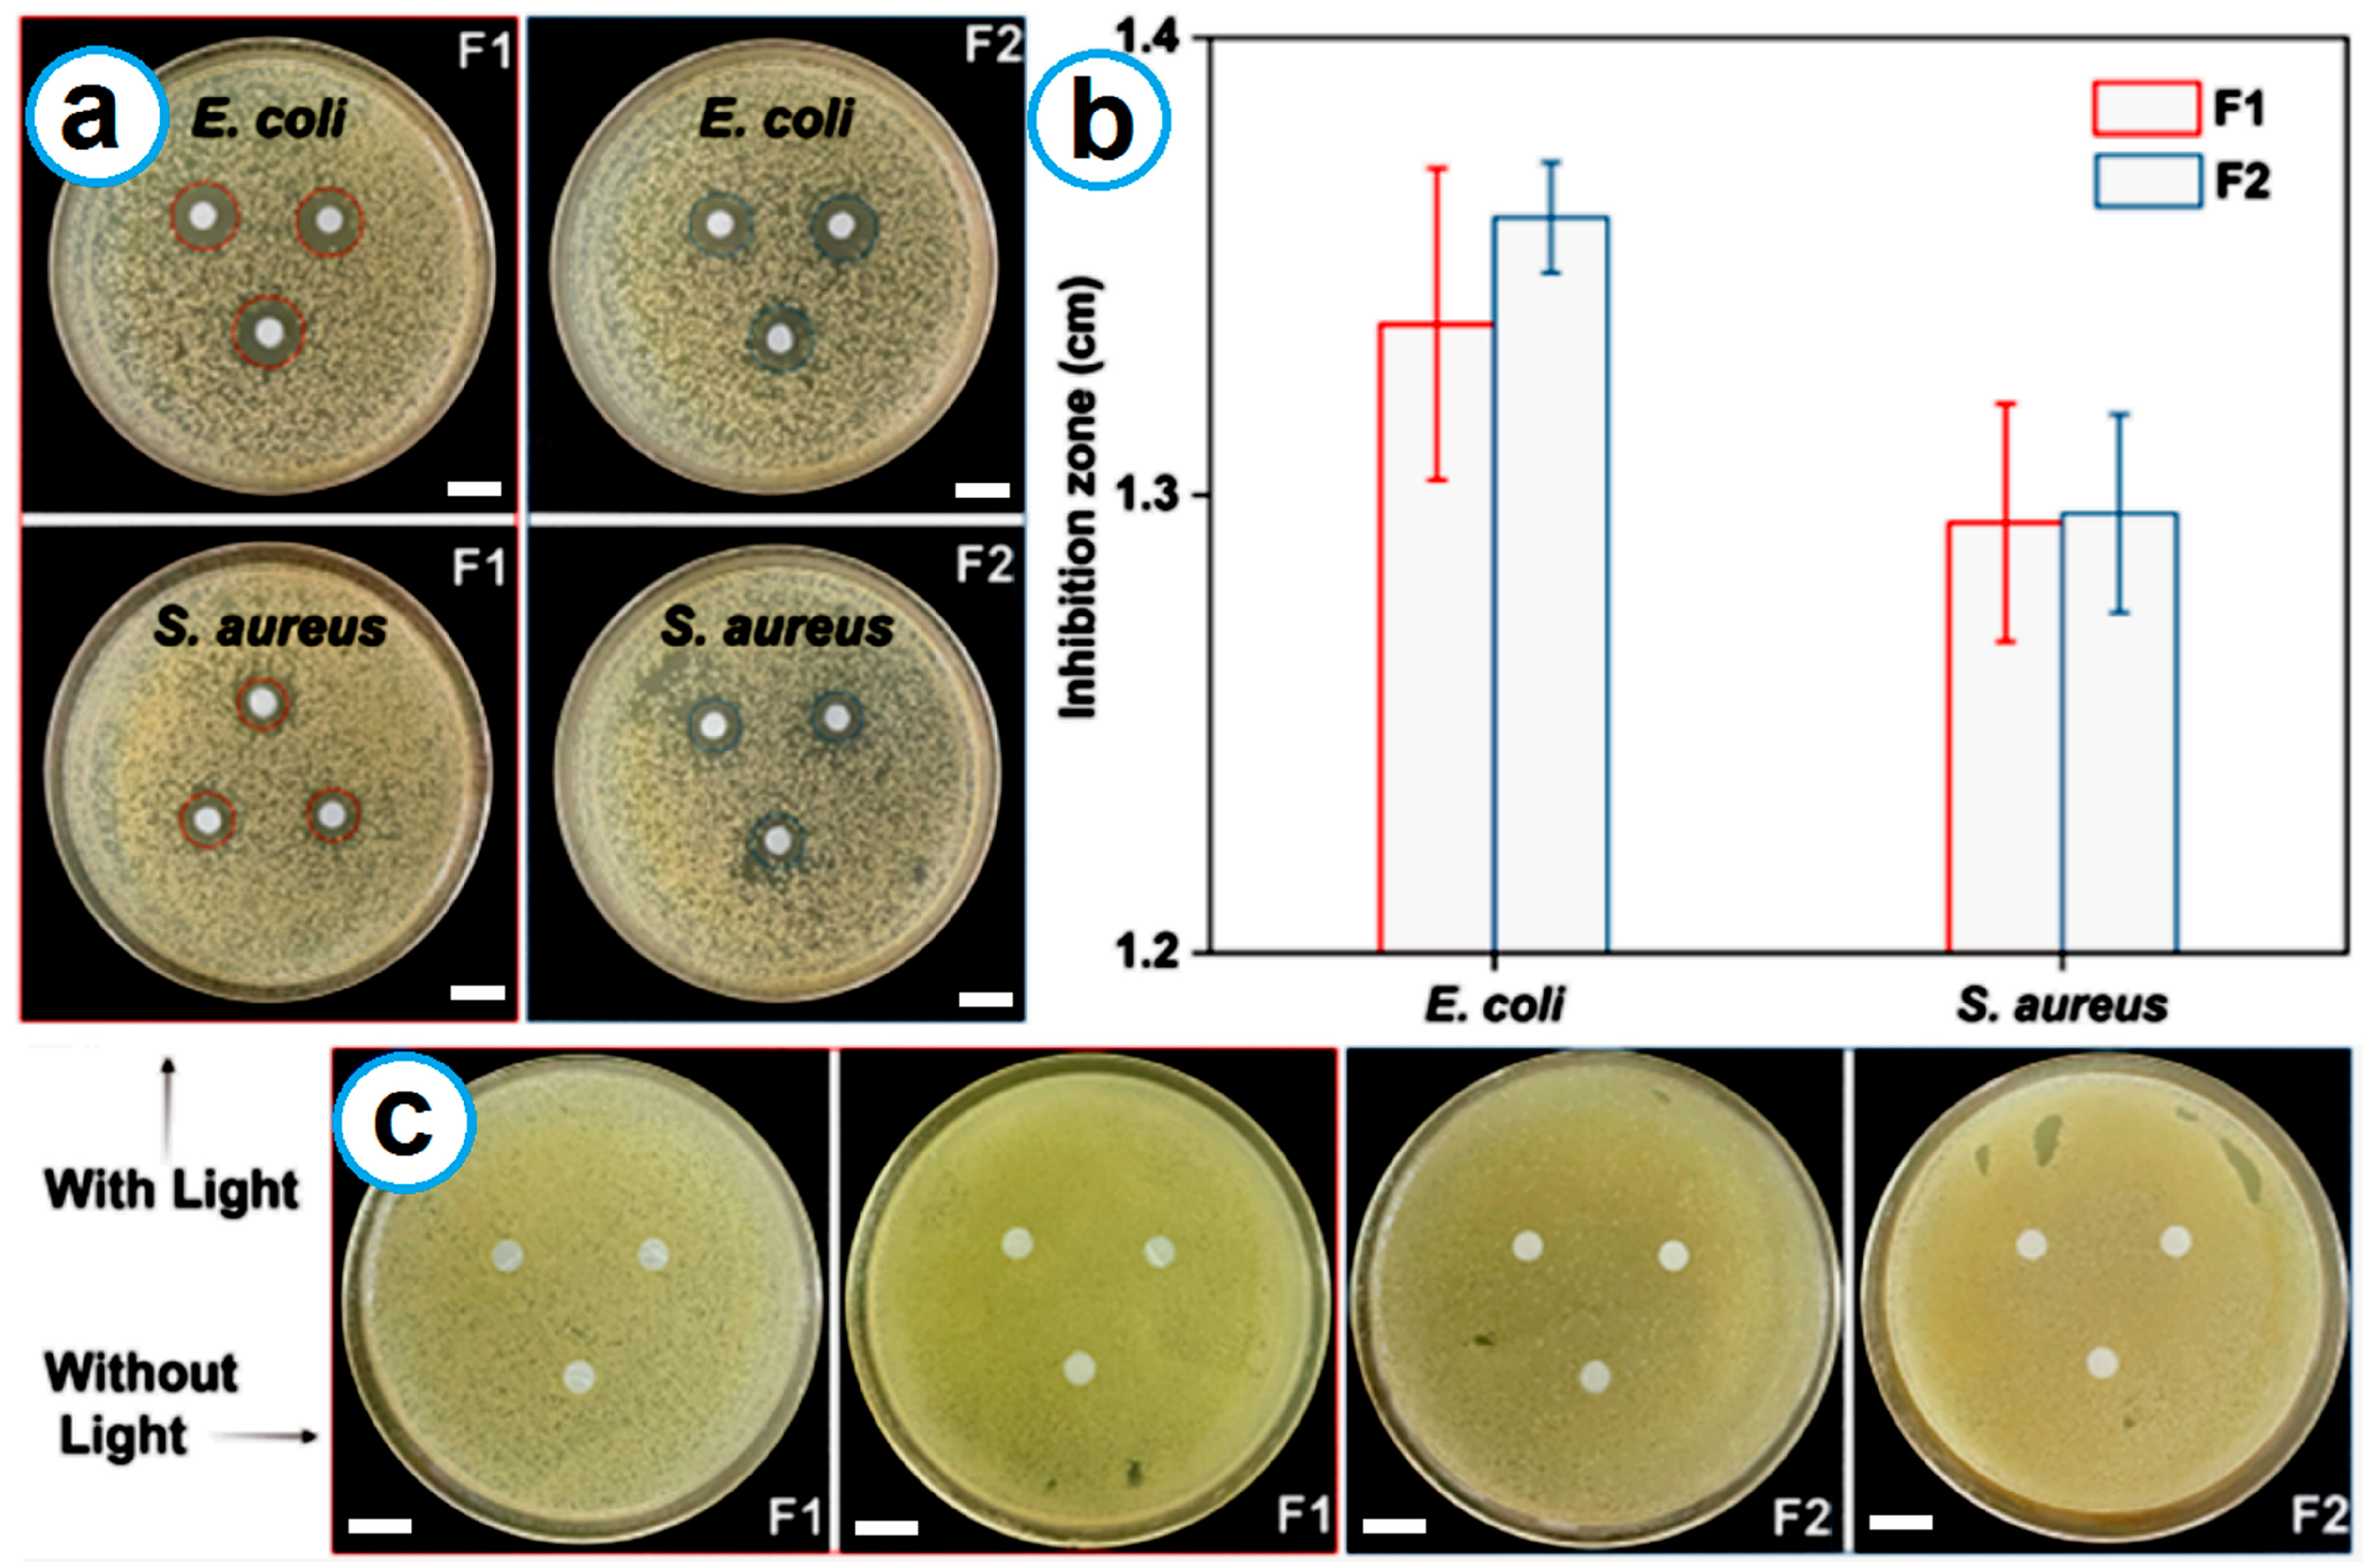
Ijms 25 09556 g007

Shell Distribution of Vitamin K3 within Reinforced Electrospun Nanofibers for Improved Photo-Antibacterial Performance
Abstract
1. Introduction
2. Results and Discussion
2.1. Implementation of Coaxial Electrospinning
2.2. Morphology and Inner Structure
2.3. Physical State and Compatibility
2.4. Mechanical Properties
2.5. Water Contact Angle Tests
2.6. Photoreaction Tests
2.7. Antibacterial Tests
3. Materials and Methods
3.1. Materials
3.2. Preparing Nanofibers Using Coaxial Electrospinning
3.3. Characterizations
3.4. Statistical Analysis
4. Conclusions
Author Contributions
Funding
Institutional Review Board Statement
Informed Consent Statement
Data Availability Statement
Acknowledgments
Conflicts of Interest
References
- Dolez, P.I.; Marsha, S.; McQueen, R.H. Fibers and Textiles for Personal Protective Equipment: Review of Recent Progress and Perspectives on Future Developments. Textiles 2022, 2, 349–381. [Google Scholar] [CrossRef]
- Karim, N.; Afroj, S.; Lloyd, K.; Oaten, L.C.; Andreeva, D.V.; Carr, C.; Farmery, A.D.; Kim, I.-D.; Novoselov, K.S. Sustainable Personal Protective Clothing for Healthcare Applications: A Review. ACS Nano 2020, 14, 12313–12340. [Google Scholar] [CrossRef]
- Agarwal, R. The Personal Protective Equipment Fabricated via 3D Printing Technology During COVID-19. Ann. 3D Print. Med. 2022, 5, 100042. [Google Scholar] [CrossRef] [PubMed]
- Han, C.; Han, X.; Han, J.; He, M.; Peng, S.; Zhang, C.; Liu, X.; Gou, J.; Wang, J. Light-Stimulated Synaptic Transistor with High PPF Feature for Artificial Visual Perception System Application. Adv. Funct. Mater. 2022, 32, 2113053. [Google Scholar] [CrossRef]
- Shi, J.; Li, H.; Xu, F.; Tao, X. Materials in Advanced Design of Personal Protective Equipment: A Review. Mater. Today Adv. 2021, 12, 100171. [Google Scholar] [CrossRef]
- Cook, T.M. Personal Protective Equipment During the Coronavirus Disease (COVID) 2019 Pandemic—A Narrative Review. Anaesthesia 2020, 75, 920–927. [Google Scholar] [CrossRef]
- Su, X.; Jia, C.; Xiang, H.; Zhu, M. Research Progress in Preparation, Properties, and Applications of Medical Protective Fiber Materials. Appl. Mater. Today 2023, 32, 101792. [Google Scholar] [CrossRef]
- Hirschmann, M.T.; Hart, A.; Henckel, J.; Sadoghi, P.; Seil, R.; Mouton, C. COVID-19 Coronavirus: Recommended Personal Protective Equipment for the Orthopaedic and Trauma Surgeon. Knee Surg. Sports Traumatol. Arthrosc. 2020, 28, 1690–1698. [Google Scholar] [CrossRef] [PubMed]
- Zeng, Y.; Wang, L.; Zhang, L.; Yu, J.Q. An Acid Resistant Nanofiltration Membrane Prepared From a Precursor of Poly(S-Triazine-Amine) by Interfacial Polymerization. J. Membr. Sci. 2018, 546, 225–233. [Google Scholar] [CrossRef]
- Weng, R.; Huang, X.; Liao, D.; Xu, S.; Peng, L.; Liu, X. A Novel Cellulose/Chitosan Composite Nanofiltration Membrane Prepared with Piperazine and Trimesoyl Chloride by Interfacial Polymerization. RSC Adv. 2020, 10, 1309–1318. [Google Scholar] [CrossRef]
- Tran, N.T.; Kim, J.; Othman, M.R. Microporous ZIF-8 Membrane Prepared from Secondary Growth for Improved Propylene Permeance and Selectivity. Microporous Mesoporous Mater. 2019, 285, 178–184. [Google Scholar] [CrossRef]
- Kidambi, P.R.; Mariappan, D.D.; Dee, N.T.; Vyatskikh, A.; Zhang, S.; Karnik, R.; Hart, A.J. A Scalable Route to Nanoporous Large-Area Atomically Thin Graphene Membranes by Roll-to-Roll Chemical Vapor Deposition and Polymer Support Casting. ACS Appl. Mater. Interfaces 2018, 10, 10369–10378. [Google Scholar] [CrossRef] [PubMed]
- Liu, A.; Kovacik, P.; Peard, N.; Tian, W.; Goktas, H.; Lau, J.; Dunn, B.; Gleason, K.K. Monolithic Flexible Supercapacitors Integrated into Single Sheets of Paper and Membrane via Vapor Printing. Adv. Mater. 2017, 29, 1606091. [Google Scholar] [CrossRef]
- Oh, H.J.; McGrath, J.E.; Paul, D.R. Water and Salt Transport Properties of Disulfonated Poly(Arylene Ether Sulfone) Desalination Membranes Formed by Solvent-Free Melt Extrusion. J. Membr. Sci. 2018, 546, 234–245. [Google Scholar] [CrossRef]
- Xu, D.; Zheng, X.; Xiao, R. Hydrophilic Nanofibrous Composite Membrane Prepared by Melt-Blending Extrusion for Effective Separation of Oil/Water Emulsion. RSC Adv. 2017, 7, 7108–7115. [Google Scholar] [CrossRef]
- Sun, Y.; Zhou, J.; Zhang, Z.; Yu, D.-G.; Bligh, S.W.A. Integrated Janus Nanofibers Enabled by a Co-Shell Solvent for Enhancing Icariin Delivery Efficiency. Int. J. Pharm. 2024, 658, 124180. [Google Scholar] [CrossRef]
- Gong, W.; Yang, W.; Zhou, J.; Zhang, S.; Yu, D.-G.; Liu, P. Engineered Beads-on-a-String Nanocomposites for an Improved Drug Fast-Sustained Bi-Stage Release. Nanocomposites 2024, 10, 240–253. [Google Scholar] [CrossRef]
- Mao, H.; Zhou, J.; Yan, L.; Zhang, S.; Yu, D.-G. Hybrid Films Loaded with 5-Fluorouracil and Reglan for Synergistic Treatment of Colon Cancer via Asynchronous Dual-Drug Delivery. Front. Bioeng. Biotechnol. 2024, 12, 1398730. [Google Scholar] [CrossRef] [PubMed]
- Chen, S.; Zhou, J.; Fang, B.; Ying, Y.; Yu, D.-G.; He, H. Three EHDA Processes from a Detachable Spinneret for Fabricating Drug Fast Dissolution Composites. Macromol. Mater. Eng. 2024, 309, 2300361. [Google Scholar] [CrossRef]
- Ji, Y.; Zhao, H.; Liu, H.; Zhao, P.; Yu, D.-G. Electrosprayed Stearic-Acid-Coated Ethylcellulose Microparticles for an Improved Sustained Release of Anticancer Drug. Gels 2023, 9, 700. [Google Scholar] [CrossRef]
- Chen, X.; Yan, S.; Wen, S.; Chen, J.; Xu, J.; Wang, C.; Lu, X. Chelating Adsorption-Engaged Synthesis of Ultrafine Iridium Nanoparticles Anchored on N-Doped Carbon Nanofibers Toward Highly Efficient Hydrogen Evolution in Both Alkaline and Acidic Media. J. Colloid Interface Sci. 2023, 641, 782–790. [Google Scholar] [CrossRef] [PubMed]
- Li, D.; Yue, G.; Li, S.; Liu, J.; Li, H.; Gao, Y.; Liu, J.; Hou, L.; Liu, X.; Cui, Z.; et al. Fabrication and Applications of Multi-Fluidic Electrospinning Multi-Structure Hollow and Core–Shell Nanofibers. Engineering 2022, 13, 116–127. [Google Scholar] [CrossRef]
- Wang, X.; Feng, C. Chiral Fiber Supramolecular Hydrogels for Tissue Engineering. WIREs Nanomed. Nanobiotechnol. 2023, 15, e1847. [Google Scholar] [CrossRef]
- Lu, H.; Zhao, Y.; Qin, S.; Zhang, Y.; Liu, J.; Zhang, J.; Feng, C.; Zhao, W. Fluorine Substitution Tunes the Nanofiber Chirality of SupraMolecular Hydrogels to Promote Cell Adhesion and Proliferation. Adv. Fiber Mater. 2023, 5, 377–387. [Google Scholar] [CrossRef]
- de Farias, B.S.; Rizzi, F.Z.; Ribeiro, E.S.; Diaz, P.S.; Sant’Anna Cadaval Junior, T.R.; Dotto, G.L.; Khan, M.R.; Manoharadas, S.; de Almeida Pinto, L.A.; dos Reis, G.S. Influence of Gelatin Type on Physicochemical Properties of Electrospun Nanofibers. Sci. Rep. 2023, 13, 15195. [Google Scholar] [CrossRef] [PubMed]
- Kang, S.; Hou, S.; Chen, X.; Yu, D.-G.; Wang, L.; Li, X.; Williams, G.R. Energy-Saving Electrospinning with a Concentric Teflon-Core Rod Spinneret to Create Medicated Nanofibers. Polymers 2020, 12, 2421. [Google Scholar] [CrossRef] [PubMed]
- Sun, L.; Zhou, J.; Chen, Y.; Yu, D.-G.; Liu, P. A Combined Electrohydrodynamic Atomization Method for Preparing Nanofiber/Microparticle Hybrid Medicines. Front. Bioeng. Biotechnol. 2023, 11, 1308004. [Google Scholar] [CrossRef]
- Qian, C.; Liu, Y.; Chen, S.; Zhang, C.; Chen, X.; Liu, Y.; Liu, P. Electrospun Core–Sheath PCL Nanofibers Loaded with nHA and SimvasTatin and their Potential Bone Regeneration Applications. Front. Bioeng. Biotechnol. 2023, 11, 1205252. [Google Scholar] [CrossRef]
- Zhang, Y.; Lu, Y.; Li, Y.; Xu, Y.; Song, W. Poly(Glutamic Acid)-Engineered Nanoplatforms for Enhanced Cancer Phototherapy. Curr. Drug Delivery 2024, 21, 326–338. [Google Scholar] [CrossRef]
- Zhou, J.; Yi, T.; Zhang, Z.; Yu, D.-G.; Liu, P.; Wang, L.; Zhu, Y. Electrospun Janus Core (Ethyl Cellulose//Polyethylene Oxide) @ Shell (Hydroxypropyl Methyl Cellulose Acetate Succinate) Hybrids for an Enhanced Colon-Targeted Prolonged Drug Absorbance. Adv. Compos. Hybrid Mater. 2023, 6, 189. [Google Scholar] [CrossRef]
- Xu, L.; Li, Q.; Wang, H.; Liu, H.; Yu, D.-G.; Bligh, S.-W.A.; Lu, X. Electrospun Multi-Functional Medicated Tri-Section Janus Nanofibers for an Improved Anti-Adhesion Tendon Repair. Chem. Eng. J. 2024, 492, 152359. [Google Scholar] [CrossRef]
- Lv, H.; Liu, Y.; Zhou, J.; Bai, Y.; Shi, H.; Yue, B.; Shen, S.; Yu, D.-G. Efficient Piezophotocatalysis of ZnO@PVDF Coaxial Nanofibers Modified with BiVO4 and Ag for the Simultaneous Generation of H2O2 and Removal of Pefloxacin and Cr(VI) in Water. Chem. Eng. J. 2024, 484, 149514. [Google Scholar] [CrossRef]
- Zhang, Z.; Liu, H.; Yu, D.-G.; Bligh, S.-W.A. Alginate-Based Electrospun Nanofibers and the Enabled Drug Controlled Release Profiles: A Review. Biomolecules 2024, 14, 789. [Google Scholar] [CrossRef]
- Yu, D.-G.; Gong, W.; Zhou, J.; Liu, Y.; Zhu, Y.; Lu, X. Engineered Shapes Using Electrohydrodynamic Atomization for an Improved Drug Delivery. WIREs Nanomed. Nanobiotechnol. 2024, 16, e1964. [Google Scholar] [CrossRef] [PubMed]
- Zhang, Z.; Wisuthiphaet, N.; Nitin, N.; Wang, L.; Kawakita, R.; Jeoh, T.; Sun, G. Photoactive Water-Soluble Vitamin K: A Novel Amphiphilic Photoinduced Antibacterial Agent. ACS Sustain. Chem. Eng. 2021, 9, 8280–8294. [Google Scholar] [CrossRef]
- Yang, L.; Zhang, Y.; Hu, X.; Shiu, B.-C.; Lou, C.-W.; Lin, J.-H.; Li, T.-T. Photodynamic Rechargeable Nanofibrous Membranes with High-Efficient Antibacterial/Antiviral Properties for Medical Protection. J. Ind. Eng. Chem. 2023, 120, 410–420. [Google Scholar] [CrossRef]
- Zhao, Y.; Liu, Y.; Tian, C.; Liu, Z.; Wu, K.; Zhang, C.; Han, X. Construction of Antibacterial Photothermal PCL/AgNPs/BP Nanofibers for Infected Wound Healing. Mater. Des. 2023, 226, 111670. [Google Scholar] [CrossRef]
- Dong, M.; Sun, X.; Bu, T.; Zhang, H.; Wang, J.; He, K.; Li, L.; Li, Z.; Wang, L. 3D/2D TMSs/TiO2 Nanofibers Heterojunctions for Photodynamic-Photothermal and Oxidase-Like Synergistic Antibacterial Therapy Co-Driven by VIS and NIR Biowindows. Compos. Part B 2022, 230, 109498. [Google Scholar] [CrossRef]
- Zhang, S.; Chen, H.; Ma, H.; Yu, J.; Liu, L.; Fan, Y. A MoS2QDs/Chitin Nanofiber Composite for Improved Antibacterial and Food Packaging. Int. J. Biol. Macromol. 2022, 209, 737–746. [Google Scholar] [CrossRef] [PubMed]
- Ci, H.; Ma, L.; Liu, X.; Liang, Y.; Zheng, Y.; Li, Z.; Zhu, S.; Cui, Z.; Wu, S. Photo-Excited Antibacterial Poly(ε-Caprolactone)@MoS2/ZnS Hybrid Nanofibers. Chem. Eng. J. 2022, 434, 134764. [Google Scholar] [CrossRef]
- Belete, T.M. Novel Targets to Develop New Antibacterial Agents and Novel Alternatives to Antibacterial Agents. Hum. Microbiome J. 2019, 11, 100052. [Google Scholar] [CrossRef]
- Tang, S.; Ruan, Z.; Ma, A.; Wang, D.; Kou, J. Effect of Vitamin K on Wound Healing: A Systematic Review and Meta-Analysis Based on Preclinical Studies. Front. Pharmacol. 2022, 13, 1063349. [Google Scholar] [CrossRef] [PubMed]
- Tintino, S.R.; Oliveira-Tintino, C.D.M.; Campina, F.F.; Weslley Limaverde, P.; Pereira, P.S.; Siqueira-Junior, J.P.; Coutinho, H.D.M.; Quintans-Júnior, L.J.; da Silva, T.G.; Leal-Balbino, T.C.; et al. Vitamin K Enhances the Effect of Antibiotics Inhibiting the Efflux Pumps of Staphylococcus Aureus Strains. Med. Chem. Res. 2018, 27, 261–267. [Google Scholar] [CrossRef]
- Yıldırım, H.; Yıldız, M.; Bayrak, N.; Mataracı-Kara, E.; Radwan, M.O.; Jannuzzi, A.T.; Otsuka, M.; Fujita, M.; TuYuN, A.F. Promising Antibacterial and Antifungal Agents Based on Thiolated Vitamin K3 Analogs: Synthesis, Bioevaluation, Molecular Docking. Pharmaceuticals 2022, 15, 586. [Google Scholar] [CrossRef] [PubMed]
- Chadar, D.; Camilles, M.; Patil, R.; Khan, A.; Weyhermüller, T.; Salunke-Gawali, S. Synthesis and Characterization of n-Alkylamino Derivatives of Vitamin K3: Molecular Structure of 2-Propylamino-3-Methyl-1,4-Naphthoquinone and Antibacterial Activities. J. Mol. Struct. 2015, 1086, 179–189. [Google Scholar] [CrossRef]
- Zhou, J.; Chen, Y.; Liu, Y.; Huang, T.; Xing, J.; Ge, R.; Yu, D.-G. Electrospun Medicated Gelatin/Polycaprolactone Janus Fibers for Photothermal-Chem Combined Therapy of Liver Cancer. Int. J. Biol. Macromol. 2024, 269, 132113. [Google Scholar] [CrossRef]
- Chen, X.; Liu, Y.; Liu, P. Electrospun Core–Sheath Nanofibers with a Cellulose Acetate Coating for the Synergistic Release of Zinc Ion and Drugs. Mol. Pharm. 2024, 21, 173–182. [Google Scholar] [CrossRef]
- Zhao, P.; Zhou, K.; Xia, Y.; Qian, C.; Yu, D.-G.; Xie, Y.; Liao, Y. Electrospun Trilayer Eccentric Janus Nanofibers for a Combined Treatment of Periodontitis. Adv. Fiber Mater. 2024, 6, 1053–1073. [Google Scholar] [CrossRef]
- Wang, M.; Hou, J.; Yu, D.-G.; Li, S.; Zhu, J.; Chen, Z. Electrospun Tri-Layer Nanodepots for Sustained Release of Acyclovir. J. Alloys Compd. 2020, 846, 156471. [Google Scholar] [CrossRef]
- Liu, Y.; Chen, X.; Lin, X.; Yan, J.; Yu, D.-G.; Liu, P.; Yang, H. Electrospun Multi-Chamber Core–Shell Nanofibers and Their Controlled Release Behaviors: A Review. WIREs Nanomed. Nanobiotechnol. 2024, 16, e1954. [Google Scholar] [CrossRef]
- Cai, M.; He, H.; Zhang, X.; Yan, X.; Li, J.; Chen, F.; Yuan, D.; Ning, X. Efficient Synthesis of PVDF/PI Side-by-Side Bicomponent Nanofiber Membrane with Enhanced Mechanical Strength and Good Thermal Stability. Nanomaterials 2019, 9, 39. [Google Scholar] [CrossRef] [PubMed]
- Cai, M.; Zhu, J.; Yang, C.; Gao, R.; Shi, C.; Zhao, J. A Parallel Bicomponent TPU/PI Membrane with Mechanical Strength Enhanced Isotropic Interfaces used as Polymer Electrolyte for Lithium-Ion Battery. Polymers 2019, 11, 185. [Google Scholar] [CrossRef]
- Liu, W.; Zhong, T.; Liu, T.; Zhang, J.; Liu, H. Preparation and Characterization of Electrospun Conductive Janus Nanofibers with Polyaniline. ACS Appl. Polym. Mater. 2020, 2, 2819–2829. [Google Scholar] [CrossRef]
- Liu, Q.; Xia, M.; Chen, J.; Tao, Y.; Wang, Y.; Liu, K.; Li, M.; Wang, W.; Wang, D. High Performance Hybrid Al2O3/Poly(Vinyl Alcohol-Co-Ethylene) Nanofibrous Membrane for Lithium-ion Battery Separator. Electrochim. Acta 2015, 176, 949–955. [Google Scholar] [CrossRef]
- Luzi, F.; Puglia, D.; Dominici, F.; Fortunati, E.; Giovanale, G.; Balestra, G.M.; Torre, L. Effect of Gallic Acid and Umbelliferone on Thermal, Mechanical, Antioxidant and Antimicrobial Properties of Poly (Vinyl Alcohol-Co-Ethylene) Films. Polym. Degrad. Stab. 2018, 152, 162–176. [Google Scholar] [CrossRef]
- Huang, K.; Yang, X.; Ma, Y.; Sun, G.; Nitin, N. Incorporation of Antimicrobial Bio-Based Carriers onto Poly(Vinyl Alcohol-Co-Ethylene) Surface for Enhanced Antimicrobial Activity. ACS Appl. Mater. Interfaces 2021, 13, 36275–36285. [Google Scholar] [CrossRef]
- Jayeoye, T.J.; Nwabor, O.F.; Rujiralai, T. Synthesis of Highly Stable and Dispersed Silver Nanoparticles/Poly(Vinyl Alcohol-Co-Ethylene Glycol)/Poly(3-Aminophenyl Boronic Acid) Nanocomposite: Characterization and Antibacterial, Hemolytic and Cytotoxicity Studies. J. Ind. Eng. Chem. 2020, 89, 288–300. [Google Scholar] [CrossRef]
- Ni, Y.; Yan, K.; Xu, F.; Zhong, W.; Zhao, Q.; Liu, K.; Yan, K.; Wang, D. Synergistic Effect on TiO2 Doped Poly (Vinyl Alcohol-Co-Ethylene) Nanofibrous Film for Filtration and Photocatalytic Degradation of Methylene Blue. Compos. Commun. 2019, 12, 112–116. [Google Scholar] [CrossRef]
- Yi, Z.; Cheng, P.; Chen, J.; Liu, K.; Liu, Q.; Li, M.; Zhong, W.; Wang, W.; Lu, Z.; Wang, D. PVA-Co-PE Nanofibrous Filter Media with Tailored Three-Dimensional Structure for High Performance and Safe Aerosol Filtration via Suspension-Drying Procedure. Ind. Eng. Chem. Res. 2018, 57, 9269–9280. [Google Scholar] [CrossRef]
- Liang, M.; Wang, F.; Liu, M.; Yu, J.; Si, Y.; Ding, B. N-Halamine Functionalized Electrospun Poly(Vinyl Alcohol-Co-Ethylene) Nanofibrous Membranes with Rechargeable Antibacterial Activity for Bioprotective Applications. Adv. Fiber Mater. 2019, 1, 126–136. [Google Scholar] [CrossRef]
- Zhang, Z.; El-Moghazy, A.Y.; Wisuthiphaet, N.; Nitin, N.; Castillo, D.; Murphy, B.G.; Sun, G. Daylight-Induced Antibacterial and Antiviral Nanofibrous Membranes Containing Vitamin K Derivatives for Personal Protective Equipment. ACS Appl. Mater. Interfaces 2020, 12, 49416–49430. [Google Scholar] [CrossRef]
- Kandhasamy, S.; Liang, B.; Yang, D.-P.; Zeng, Y. Antibacterial Vitamin K3 Carnosine Peptide-Laden Silk Fibroin Electrospun Fibers for Improvement of Skin Wound Healing in Diabetic Rats. ACS Appl. Bio Mater. 2021, 4, 4769–4788. [Google Scholar] [CrossRef] [PubMed]
- Sheng, L.; Zhang, Z.; Sun, G.; Wang, L. Light-Driven Antimicrobial Activities of Vitamin K3 Against Listeria Monocytogenes, Escherichia Coli O157:H7 and Salmonella Enteritidis. Food Control 2020, 114, 107235. [Google Scholar] [CrossRef]
- Negri, L.B.; Mannaa, Y.; Korupolu, S.; Farinelli, W.A.; Anderson, R.R.; Gelfand, J.A. Vitamin K3 (Menadione) is a Multifunctional Microbicide Acting as a Photosensitizer and Synergizing with Blue Light to Kill Drug-Resistant Bacteria in Biofilms. J. Photochem. Photobiol. B 2023, 244, 112720. [Google Scholar] [CrossRef]
- Shariatzadeh, F.J.; Currie, S.; Logsetty, S.; Spiwak, R.; Liu, S. Enhancing Wound Healing and Minimizing Scarring: A Comprehensive Review of Nanofiber Technology in Wound Dressings. Prog. Mater. Sci. 2024, 147, 101350. [Google Scholar] [CrossRef]
- Yan, S.; Qian, Y.; Haghayegh, M.; Xia, Y.; Yang, S.; Cao, R.; Zhu, M. Electrospun Organic/Inorganic Hybrid Nanofibers for Accelerating Wound Healing: A Review. J. Mater. Chem. B 2024, 12, 3171–3190. [Google Scholar] [CrossRef]
- Ajalli, N.; Pourmadadi, M.; Yazdian, F.; Abdouss, M.; Rashedi, H.; Rahdar, A. PVA Based Nanofiber Containing GO Modified with Cu Nanoparticles and Loaded Curcumin; High Antibacterial Activity with Acceleration Wound Healing. Curr. Drug Delivery 2023, 20, 1569–1583. [Google Scholar] [CrossRef] [PubMed]
- Zhang, S.; Yang, W.; Gong, W.; Lu, Y.; Yu, D.-G.; Liu, P. Recent Progress of Electrospun Nanofibers as Burning Dressings. RSC Adv. 2024, 14, 14374–14391. [Google Scholar] [CrossRef]
- Zhang, X.; Yu, N.; Ren, Q.; Niu, S.; Zhu, L.; Hong, L.; Cui, K.; Wang, X.; Jiang, W.; Wen, M.; et al. Janus Nanofiber Membranes with Photothermal-Enhanced Biofluid Drainage and Sterilization for Diabetic Wounds. Adv. Funct. Mater. 2024, 34, 2315020. [Google Scholar] [CrossRef]
- Peng, W.; Wang, L.; Zhang, M.; Yu, D.-G.; Li, X. Biodegradable Flexible Conductive Film Based on Sliver Nanowires and PLA Electrospun Fibers. J. Appl. Polym. Sci. 2024, 141, e55433. [Google Scholar] [CrossRef]
- Liu, K.; Cheng, P.; Wang, Y.; Zhong, W.; Lu, Z.; Li, M.; Liu, Q.; Wang, W.; Zhu, Q.; Wang, D. Concurrent Filtration and Inactivation of Bacteria Using Poly(Vinyl Alcohol-Co-Ethylene) Nanofibrous Membrane Facilely Modified Using Chitosan and Graphene Oxide. Environ. Sci. Nano 2017, 4, 385–395. [Google Scholar] [CrossRef]
- Baek, S.; Park, H.; Park, Y.; Kang, H.; Lee, D. Development of a Lidocaine-Loaded Alginate/CMC/PEO Electrospun Nanofiber Film and Application As an Anti-Adhesion Barrier. Polymers 2020, 12, 618. [Google Scholar] [CrossRef]
- Peng, C.; Zhao, B.; Meng, X.; Ye, X.; Luo, T.; Xin, X.; Wen, Z. Effect of NiO Addition on the Sintering and Electrochemical Properties of BaCe0.55Zr0.35Y0.1O3-δ Proton-Conducting Ceramic Electrolyte. Membranes 2024, 14, 61. [Google Scholar] [CrossRef] [PubMed]
- Fan, J.; Ma, J.; Zhu, L.; Wang, H.; Hao, W.; Min, Y.; Bi, Q.; Li, G. Silver Nanowires Cascaded Layered Double Hydroxides Nanocages with Enhanced Directional Electron Transport for Efficient Electrocatalytic Oxygen Evolution. Small 2024, 20, 2309859. [Google Scholar] [CrossRef] [PubMed]
- Śmigiel-Gac, N.; Smola-Dmochowska, A.; Jelonek, K.; Musiał-Kulik, M.; Barczyńska-Felusiak, R.; Rychter, P.; Lewicka, K.; Dobrzyński, P. Bactericidal Biodegradable Linear Polyamidoamines Obtained with the Use of Endogenous Polyamines. Int. J. Mol. Sci. 2024, 25, 2576. [Google Scholar] [CrossRef]
- Niesyto, K.; Keihankhadiv, S.; Mazur, A.; Mielańczyk, A.; Neugebauer, D. Ionic Liquid-Based Polymer Matrices for Single and Dual Drug Delivery: Impact of Structural Topology on Characteristics and In Vitro Delivery Efficiency. Int. J. Mol. Sci. 2024, 25, 1292. [Google Scholar] [CrossRef]
- Khalil, A.M.; Hassanin, A.H.; El-kaliuoby, M.I.; Omran, N.; Gamal, M.; El-Khatib, A.M.; Kandas, I.; Shehata, N. Innovative Antibacterial Electrospun Nanofibers Mats Depending on Piezoelectric Generation. Sci. Rep. 2022, 12, 21788. [Google Scholar] [CrossRef]
- Wang, Q.; Gao, C.; Zhai, H.; Peng, C.; Yu, X.; Zheng, X.; Zhang, H.; Wang, X.; Yu, L.; Wang, S.; et al. Electrospun Scaffolds are Not Necessarily Always Made of Nanofibers as Demonstrated by Polymeric Heart Valves for Tissue Engineering. Adv. Healthc. Mater. 2024, 30, 2303395. [Google Scholar] [CrossRef]
- Zeng, W.; Cheng, N.; Liang, X.; Hu, H.; Luo, F.; Jin, J.; Li, Y. Electrospun Polycaprolactone Nanofibrous Membranes Loaded with Baicalin for Antibacterial Wound Dressing. Sci. Rep. 2022, 12, 10900. [Google Scholar] [CrossRef]
- Zhang, T.; Li, L.; Chunta, S.; Wu, W.; Chen, Z.; Lu, Y. Enhanced Oral Bioavailability from Food Protein Nanoparticles: A Mini Review. J. Control. Release 2023, 354, 146–154. [Google Scholar] [CrossRef]
- Barnthip, N.; Teeka, J.; Kantha, P.; Teepoo, S.; Damjuti, W. Fabrication and Characterization of Polycaprolactone/Cellulose Acetate Blended Nanofiber Mats Containing Sericin and Fibroin for Biomedical Application. Sci. Rep. 2022, 12, 22370. [Google Scholar] [CrossRef]
- Man, F.; Yang, Y.; He, H.; Qi, J.; Wu, W.; Lu, Y. Establishment of in Vitro Dissolution Based on Similarity with in Vivo Dissolution: A Case Study on Aripiprazole. Mol. Pharm. 2023, 20, 2579–2588. [Google Scholar] [CrossRef]
- Zhan, Y.; Zhang, S. Design of Novel PLK4 Inhibitors as TRIM37-Amplified Breast Cancer Drugs Using 3D-QSAR, Molecular Docking, and Molecular Dynamics Simulation Methods. Mol. Simul. 2024, 50, 571–587. [Google Scholar] [CrossRef]
- Zhang, Y.; Tang, Y.; Liao, Q.; Qian, Y.; Zhu, L.; Yu, D.-G.; Xu, Y.; Lu, X.; Kim, I.; Song, W. Silver Oxide Decorated Urchin-Like Microporous Organic Polymer Composites as Versatile Antibacterial Organic Coating Materials. J. Mater. Chem. B 2024, 12, 2054–2069. [Google Scholar] [CrossRef] [PubMed]
- Riaz, Z.; Baddi, S.; Gao, F.; Feng, C. Gallic Acid-Doped Multifunctional Hybrid Hydrogel for Antioxidant and Antibacterial Studies. Eur. Polym. J. 2024, 206, 112778. [Google Scholar] [CrossRef]
- Wang, Z.; Chang, Z.; Shao, D.; Zhang, F.; Chen, F.; Li, L.; Ge, M.; Hu, R.; Zheng, X.; Wang, Y.; et al. Janus Gold Triangle-Mesoporous Silica Nanoplatforms for Hypoxia-Activated Radio-Chemo-Photothermal Therapy of Liver Cancer. ACS Appl. Mater. Interfaces 2019, 11, 34755–34765. [Google Scholar] [CrossRef] [PubMed]
- Wen, P.; Ke, W.; Dirisala, A.; Toh, K.; Tanaka, M.; Li, J. Stealth and Pseudo-Stealth Nanocarriers. Adv. Drug Delivery Rev. 2023, 198, 114895. [Google Scholar] [CrossRef]
- Lin, P.; Gu, H.; Zhuang, X.; Wang, F.; Hu, X. Controlled Release of Curcumin and Hypocrellin A from Electrospun Poly(l-Lactic Acid)/Silk Fibroin Nanofibers for Enhanced Cancer Cell Inhibition. ACS Appl. Bio Mater. 2024, 7, 8. [Google Scholar] [CrossRef]
- Wei, W.; Wildy, M.; Xu, K.; Schossig, J.; Hu, X.; Hyun, D.C.; Chen, W.; Zhang, C.; Lu, P. Advancing Nanofiber Research: Assessing Nonsolvent Contributions to Structure Using Coaxial Electrospinning. Langmuir 2023, 39, 10881–10891. [Google Scholar] [CrossRef]
- Zięba, M.; Sikorska, W.; Musioł, M.; Janeczek, H.; Włodarczyk, J.; Pastusiak, M.; Gupta, A.; Radecka, I.; Parati, M.; Tylko, G.; et al. Designing of Drug Delivery Systems to Improve the Antimicrobial Efficacy in the Periodontal Pocket Based on Biodegradable Polyesters. Int. J. Mol. Sci. 2024, 25, 503. [Google Scholar] [CrossRef]
- Patel, D.; Wei, W.; Singh, H.; Xu, K.; Beck, C.; Wildy, M.; Schossig, J.; Hu, X.; Hyun, D.C.; Chen, W.; et al. Efficient and Secure Encapsulation of a Natural Phase Change Material in Nanofibers Using Coaxial Electrospinning for Sustainable Thermal Energy Storage. ACS Sustain. Chem. Eng. 2023, 11, 11570–11579. [Google Scholar] [CrossRef] [PubMed]
- Duan, H.; Chen, H.; Qi, C.; Lv, F.; Wang, J.; Liu, Y.; Liu, Z.; Liu, Y. A Novel Electrospun Nanofiber System with PEGylated Paclitaxel Nanocrystals Enhancing the Transmucus Permeability and in situ Retention for an Efficient Cervicovaginal Cancer Therapy. Int. J. Pharm. 2024, 650, 123660. [Google Scholar] [CrossRef]
- Javadi, B.; Mohsenzadeh, M. Electrospun PEO/WPI Nanofibers With Vanillin for Food Applications. Food Biophys. 2024, 19, 425–438. [Google Scholar] [CrossRef]
- Qosim, N.; Majd, H.; Huo, S.; Edirisinghe, M.; Williams, G.R. Hydrophilic and Hydrophobic Drug Release From Core (Polyvinylpyrrolidone)-Sheath (Ethyl Cellulose) Pressure-Spun Fibers. Int. J. Pharm. 2024, 654, 123972. [Google Scholar] [CrossRef]
- Lv, Q.; Ma, X.; Zhang, C.; Han, J.; He, S.; Liu, K.; Jiang, S. Nanocellulose-Based Nanogenerators for Sensor Applications: A Review. Int. J. Biol. Macromol. 2024, 259, 129268. [Google Scholar] [CrossRef]
- Jarić, A.M.; Petrović, P.; Jurašin, D.D.; Vrsaljko, D.; Nodilo, L.N.; Kuzmić, S.; Kovačević, M.; Logarušić, M.; Slivac, I.; Komes, D. Electrospun Pullulan/Hemp Protein Nanohybrids for Sustained Release of Phenylethanoid Glycosides. Food Biopro. Technol. 2024, 27, 1–21. [Google Scholar] [CrossRef]
- El Kalaaoui, K.; Boukhriss, A.; Bili, O.; Ait Chaoui, M.; Majid, S.; El Hajaji, M.; Gmouh, S. Hybrid Polyvinyl Alcohol-Silica Antibacterial Nanofiber Fabricated by Combined Sol-Gel and Electrospinning Techniques. J. Sol-Gel Sci. Technol. 2024, 11, 1–5. [Google Scholar] [CrossRef]
- Si, Y.; Guo, C.; Xu, X.; Zhang, K.; Tan, R.; Lau, K.; Hu, J. Bioinspired Janus All-Natural Electrospinning Membranes with Directional Water Transport as Ecofriendly Dry Facial Masks. ACS Sustain. Chem. Eng. 2022, 10, 7726–7738. [Google Scholar] [CrossRef]
- Huang, K.; Si, Y.; Wu, H.; Chen, Y.; Zhang, S.; Shi, S.; Guo, C.; Hu, J. Electrosprayed Environment-Friendly Dry Triode-Like Facial Masks for Skincare. ACS Appl. Mater. Interfaces 2024, 16, 1899–1910. [Google Scholar] [CrossRef]
- Gong, X.; Ding, M.; Gao, P.; Liu, X.; Yu, J.; Zhang, S.; Ding, B. High-Performance Liquid-Repellent and Thermal–Wet Comfortable Membranes Using Triboelectric Nanostructured Nanofiber/Meshes. Adv. Mater. 2023, 35, 2305606. [Google Scholar] [CrossRef]
- Bors, W.; Michel, C.; Saran, M. On the Nature of Biochemically Generated Hydroxyl Radicals Studies using the Bleaching of p-Nitrosodimethylaniline as a Direct Assay Method. Eur. J. Biochem. 1979, 95, 621–627. [Google Scholar] [CrossRef] [PubMed]

| No. | Electrospinning | Core | Shell | Core/Shell Flow Rate (mL/h) | Voltage (kV) | Collector Distance (cm) | VE3 Content (%) |
|---|---|---|---|---|---|---|---|
| F1 | Monoaxial | -- | Fluid 1 a | 0.7 | 5.0 | 17 | 8.16% |
| F2 | Coaxial | Fluid 2 b | Fluid 1 | 0.5/0.5 | 5.0 | 5.41% |
Disclaimer/Publisher’s Note: The statements, opinions and data contained in all publications are solely those of the individual author(s) and contributor(s) and not of MDPI and/or the editor(s). MDPI and/or the editor(s) disclaim responsibility for any injury to people or property resulting from any ideas, methods, instructions or products referred to in the content. |
© 2024 by the authors. Licensee MDPI, Basel, Switzerland. This article is an open access article distributed under the terms and conditions of the Creative Commons Attribution (CC BY) license (https://creativecommons.org/licenses/by/4.0/).
Share and Cite
Gong, W.; Wang, M.-L.; Liu, Y.; Yu, D.-G.; Bligh, S.W.A. Shell Distribution of Vitamin K3 within Reinforced Electrospun Nanofibers for Improved Photo-Antibacterial Performance. Int. J. Mol. Sci. 2024, 25, 9556. https://doi.org/10.3390/ijms25179556
Gong W, Wang M-L, Liu Y, Yu D-G, Bligh SWA. Shell Distribution of Vitamin K3 within Reinforced Electrospun Nanofibers for Improved Photo-Antibacterial Performance. International Journal of Molecular Sciences. 2024; 25(17):9556. https://doi.org/10.3390/ijms25179556
Chicago/Turabian StyleGong, Wenjian, Meng-Long Wang, Yanan Liu, Deng-Guang Yu, and Sim Wan Annie Bligh. 2024. "Shell Distribution of Vitamin K3 within Reinforced Electrospun Nanofibers for Improved Photo-Antibacterial Performance" International Journal of Molecular Sciences 25, no. 17: 9556. https://doi.org/10.3390/ijms25179556
APA StyleGong, W., Wang, M.-L., Liu, Y., Yu, D.-G., & Bligh, S. W. A. (2024). Shell Distribution of Vitamin K3 within Reinforced Electrospun Nanofibers for Improved Photo-Antibacterial Performance. International Journal of Molecular Sciences, 25(17), 9556. https://doi.org/10.3390/ijms25179556

